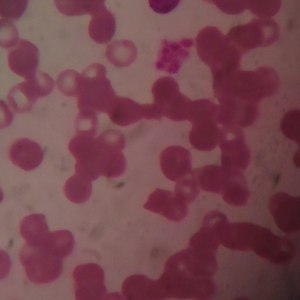
阿兹海默

阿兹海默
粥粥和小伙, 粥粥

阿兹海默
吴青峰

阿茲海默
万芳

阿兹海默
山山ci, 心塞的小猪

阿兹海默
桃溟, 落屹

阿兹海默(Single Version)
米大东

阿兹海默
关仁Side-Effect

阿兹海默
听白Olivia, 陳Alvin

阿兹海默
胡正昊

阿兹海默
吴克群

阿兹海默
尤今, 不迁, 网音圈在逃公主

阿兹海默(温柔男声)
起风等花落

阿兹海默伴奏
粥粥和小伙, 粥粥

阿兹海默
Hello晓东, 原春幼

阿兹海默
谢依璇, 紫宸vi

阿兹海默
虫某人, 亨利

阿兹海默
子衿花烬、, 心无心, 简柠

阿兹海默
杨起真

阿兹海默
花哈哈
阿兹海默
黄宏键

阿兹海默
来杯香菜奶茶

阿兹海默
池池子_

阿兹海默
一虎一虎

阿兹海默
容千

阿兹海默
幽灵, 长穆

阿兹海默
呱呱华

阿兹海默
九月知亦

阿兹海默
斯汤李奇$toneLich

阿兹海默
秋

阿兹海默
黎可辰